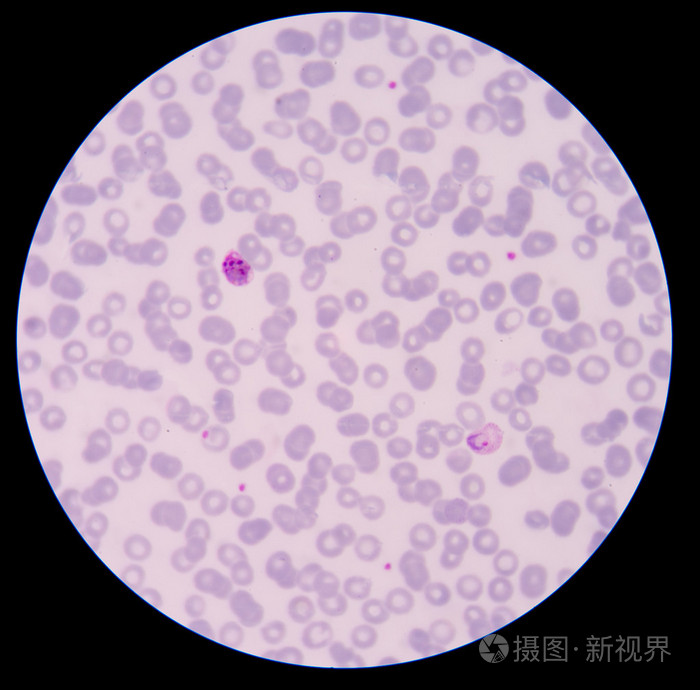
血液涂片薄膜疟疾寄生虫阳性
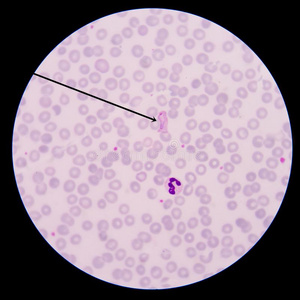
血涂片血液涂片疟疾寄生虫阳性照片
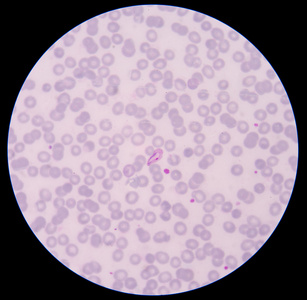
疟疾寄生虫血液涂片薄膜疟疾寄生虫阳性照片

疟疾血涂片

脑型疟疾患者的血涂片
图片尺寸640x379
常见疟原虫血片
图片尺寸1080x1439
疟原虫血涂片
图片尺寸1575x986
疟疾实验室检测最常用的方法是血涂片检查法,疟原虫快速检测试剂条rdt
图片尺寸879x590
血液涂片薄膜疟疾寄生虫阳性
图片尺寸700x686
疟疾寄生虫血液涂片: 疟疾寄生虫: 疟原虫 facifarum (工频),rin照片
图片尺寸300x300
检验科经血细胞分析复检外周血涂片确诊疟疾一例
图片尺寸976x929
疟疾病人稀薄血液涂片的显微镜照片
图片尺寸1200x615
检验科经血细胞分析复检外周血涂片确诊疟疾一例
图片尺寸870x740
疟疾血液涂片图片
图片尺寸1200x803
血液涂片薄膜疟疾寄生虫阳性
图片尺寸700x690
血液涂片: 疟疾寄生虫: 疟原虫 facifarum (工频),rin照片
图片尺寸300x300
血涂片血液涂片疟疾寄生虫阳性照片
图片尺寸300x300
血细胞分析仪测定及读片分析疟原虫感染
图片尺寸491x737
问:为什么又要涂厚的又要涂薄的啊?厚薄血涂片有何不同?
图片尺寸640x410
有一种难过叫我不在这里君安精选案例散点话疟疾
图片尺寸1080x720
疟疾感染者血膜的显微镜检查
图片尺寸1200x594
疟疾寄生虫血液涂片薄膜疟疾寄生虫阳性照片
图片尺寸307x300
近距离观察疟原虫在血红细胞中的背景.
图片尺寸1200x948
晚上下班回家路上,接到检验科通知,他们有个标本的血涂片找到疟原虫
图片尺寸640x617